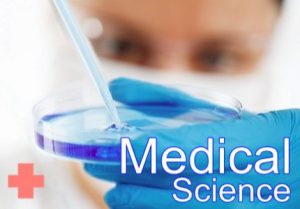

Specialist STEM Workshops
Our STEM events are highly focussed, finely honed 1-5 day workshops. They allow schools to meld creative teaching and learning styles with the use of the latest, genuinely exciting equipment (biotechnology, robotics, voting systems etc) in ways they may not yet have explored or been able to afford before.
All events have exciting movie-like scenarios and game-like challenges to maximise engagement. All are structured to enrich and extend curriculum content. All develop Higher Order Thinking skills and ensure learning is a result of problem solving. Every workshop is originally designed to challenge Able, Gifted & Talented learners and modified versions are facilitated to ensure STEM activities are available to all.
"This event was incredible. The students and staff were hooked immediately and were the most engaged I’ve ever seen them. The professionalism, preparation and organisation of this company are exemplary. I can’t recommend enough, an absolutely amazing company!""
R Austin – Assistant HOF, National CofE Academy, Nottingham
Immediate Benefits of Hosting
Our STEM events ensure your targets for STEM and Able, Gifted & Talented provision are easily met. Students are motivated by extraordinary experiences - that can make an impact on their perception of learning and of STEM subjects in the future. They may even discover a new career path by taking previously undiscovered job roles within the different workshops. In addition, the school can request a performance report for every participant to track progress. Every workshop is delivered by a highly experienced teacher and a teaching assistant with enhanced DBS forms. As a result, our workshops could save your school the cost of a supply teacher for the day.
Long-Term Benefits of Hosting
Teaching staff have an opportunity to observe an array of effective questioning techniques, activity designs and assessment strategies demonstrated during the workshop in order to build upon them. The Lead Presenter will happily discuss the pedagogy employed. Our style of provision can be adapted and applied to everyday lessons as part of the school development plan or we can build a progressive programme for your school. Both approaches allow participants to improve valuable skills throughout their schooling - giving them an advantage when applying for further education or new careers.
Our aim is to motivate students and inspire teachers with learning that is fascinating, challenging and relevant.
Check Availability & Find Out More
Fill in the form below to check a date or ask for advice. We will email you in response